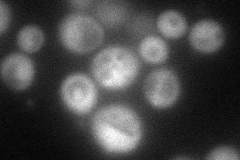
YGL047W
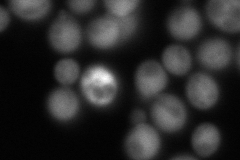
YGL047W
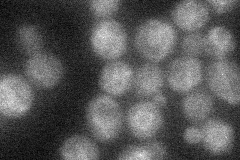
YGL047W
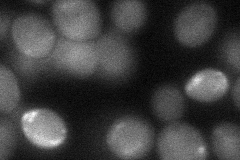
YGL047W

View description
Catalytic component of UDP-GlcNAc transferase, required for the second step of dolichyl-linked oligosaccharide synthesis; anchored to the ER membrane via interaction with Alg14p; similar to bacterial and human glycosyltransferases
Localization:
Intensity:
Fold change:
Significance:
-
C’ GFP library in SD

ER24.26 -
N' NOP1pr-GFP in SD
cytosol89.7782 -
N' TEF2pr-mCherry in SD
cytosol123.016 -
N' NATIVEpr-GFP in SD
ambiguous,ER25.1775 -
N' TEF2pr-VC and Cyto-VN in SD
cytosol39.3401 -
C’ GFP library in SD+DTT

ER25.721.06No -
C’ GFP library in SD+H2O2

ER26.981.11No -
C’ GFP library in Starvation Media

ER28.511.17No -
C’ GFP library on the background of Pup2-DaMP

ER -
C’ GFP library on the background of CCT mutant

ER22.78240.938813No
